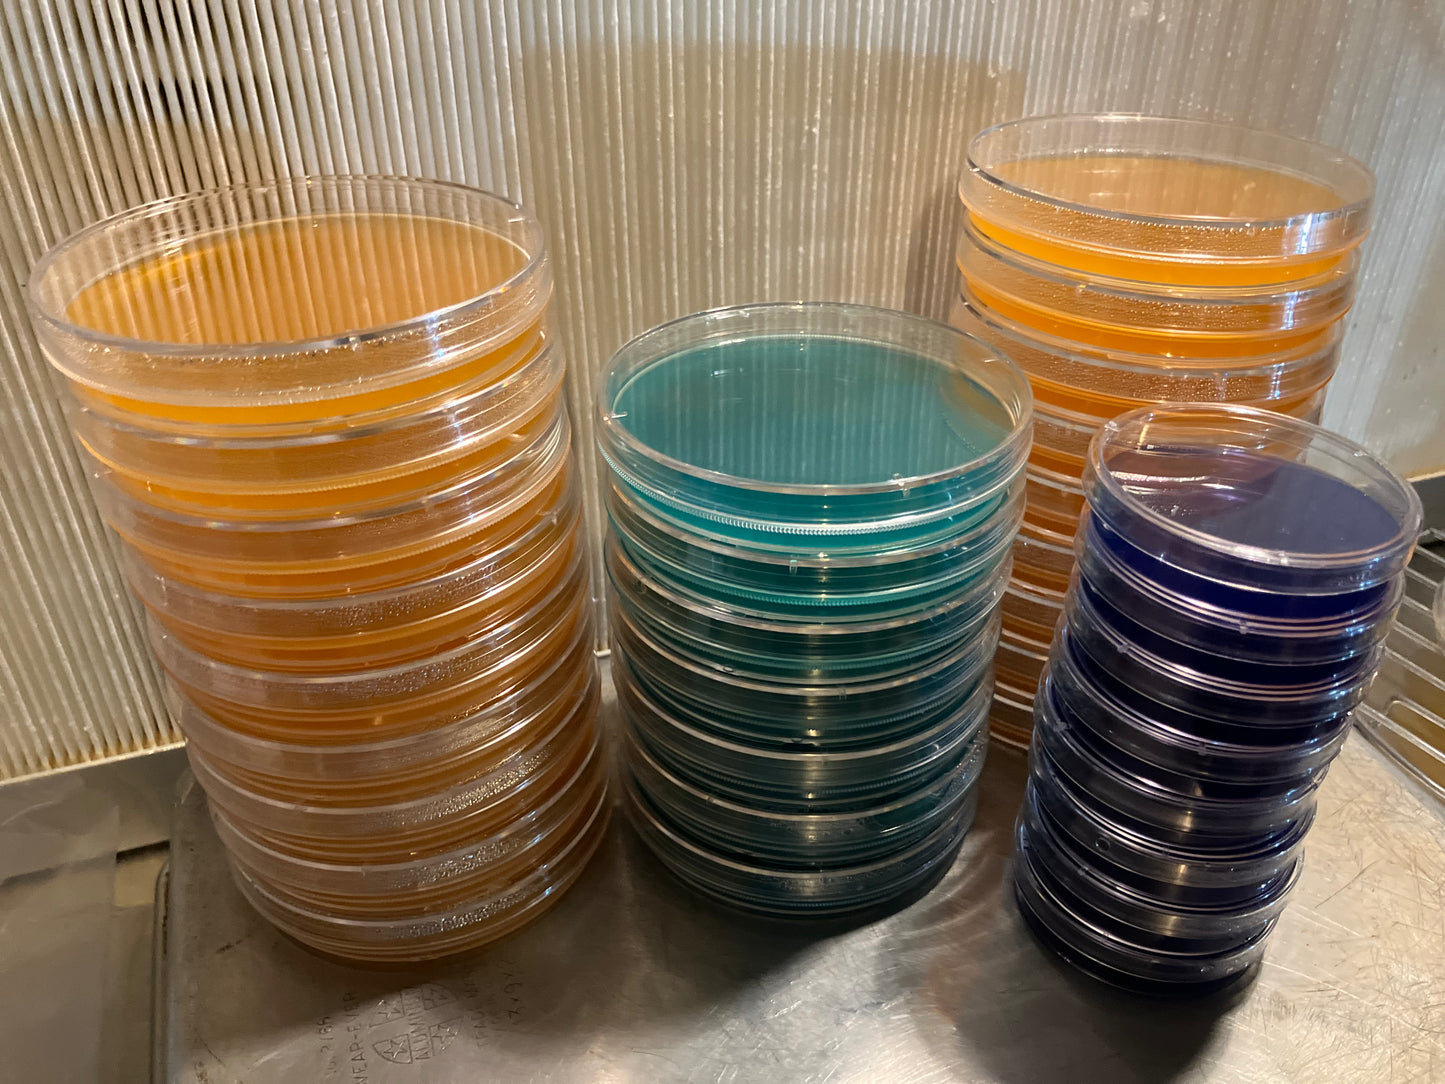

1
/
of
1
Pre Poured Sterilized MEA Petri Dishes
Pre Poured Sterilized MEA Petri Dishes
Regular price
$15.00 USD
Regular price
Sale price
$15.00 USD
Unit price
/
per
Tax included.
Couldn't load pickup availability
Pre Poured Sterilized MEA Petri Dishes
100mm x 15mm (8 per order)
Share